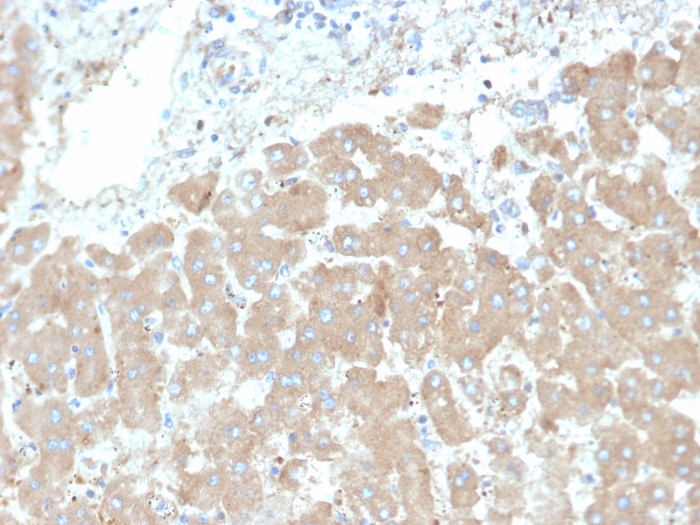

Formalin-fixed, paraffin-embedded human liver stained with Leptin Receptor Mouse Monoclonal Antibody (LEPR/4301).

SDS-PAGE Analysis of Purified Leptin Receptor Mouse Monoclonal Antibody (LEPR/4301). Confirmation of Purity and Integrity of Antibody.

Analysis of Protein Array containing more than 19,000 full-length human proteins using Monospecific Mouse Monoclonal Antibody to Leptin Receptor (LEPR/4301). Z- and S- Score: The Z-score represents the strength of a signal that a monoclonal antibody (MAb) (in combination with a fluorescently-tagged anti-IgG secondary antibody) produces when binding to a particular protein on the HuProtTM array. Z-scores are described in units of standard deviations (SD's) above the mean value of all signals generated on that array. If targets on HuProtTM are arranged in descending order of the Z-score, the S-score is the difference (also in units of SD's) between the Z-score. S-score therefore represents the relative target specificity of a MAb to its intended target. A MAb is considered to specific to its intended target, if the MAb has an S-score of at least 2.5. For example, if a MAb binds to protein X with a Z-score of 43 and to protein Y with a Z-score of 14, then the S-score for the binding of that MAb to protein X is equal to 29.
Although there is substantial evidence that body weight is physiologically regulated, the molecular basis of obesity is unknown. Five single-gene mutations in mice that result in an obese phenotype have been identified. The first such recessive obesity mutation, the obese mutation (Ob), was identified in 1950. Mutation of Ob results in profound obesity and type II diabetes as part of a syndrome that resembles morbid obesity in humans. It has been postulated that the Ob gene product may function as a component of a signaling pathway in adipose tissue that functions to regulate body fat depot size. The cloning and sequence analysis of the mouse Ob gene and its human homolog has recently been described. Ob encodes an adipose tissue-specific mRNA with a highly conserved 167 amino acid open reading frame. The predicted amino acid sequence is 84% identical between human and mouse and has the features of a secreted protein. A nonsense mutation in codon 105 has been found in the original congenic C57BL/6J Ob/Ob mouse strain. The Ob gene encodes the protein leptin. The leptin receptor, designated Ob-R, has been shown to be a single membrane-spanning receptor that most resembles the gp130 signal transducing component of the IL-6, G-CSF and LIF receptor. Ob-R mRNA is expressed in the choroid plexus and hypothalamus.
There are no reviews yet.